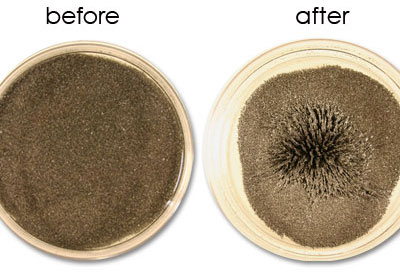
Chất lỏng MR sau khi có tác động của từ trường

Tìm hiểu công nghệ áo giáp chất lỏng
Công nghệ chế tạo áo giáp mới giúp giảm thiểu khối lượng và tăng độ linh hoạt của những bộ áo giáp lỗi thời.
Trong chiến đấu, ngoài vũ khí ra thì áo giáp là một phần không thể thiếu của mỗi binh sĩ. Từ xa xưa, ông cha ta đã biết sử dụng những vật liệu như sắt, thép, thậm chí cả gốm, rơm… làm áo giáp để bảo vệ cơ thể mình. Trải qua thăng trầm của thời gian, ý tưởng về những bộ áo giáp cũng không thay đổi nhiều là mấy. Thứ nhất, áo giáp giúp bảo vệ cơ thể của người sử dụng. Thứ hai, nó khuếch tán năng lượng của vũ khí và giảm sát thương. Tuy trong một số tình huống, áo giáp không đem lại hiệu quả lắm nhưng ít nhất, nó có thể bảo vệ cơ thể con người tránh những cú đánh chí mạng dẫn đến tử vong, đặc biệt là vũ khí tầm xa như súng.
Với sự phát triển của khoa học và công nghệ trong những năm qua, các bộ áo giáp tân tiến đã được nghiên cứu và chế tạo, áp dụng thành công trên chiến trường. Tuy nhiên, chúng vẫn còn nhiều thiếu sót, nhược điểm giống như những người đàn anh của nó. Nhiều loại áo giáp làm từ kim loại hay vải vẫn còn khá nặng và cồng kềnh. Vì vậy mà nhiều người chỉ sử dụng áo giáp để bảo vệ thân mình và đầu, ít khi sử dụng trên chân, cánh tay và cổ. Đây là nhược điểm lớn nhất của những bộ áo giáp mà chúng ta vẫn thường thấy.

Sự khác biệt giữa bộ giáp thời xa xưa và bộ giáp thời hiện đại
Và áo giáp lỏng là một bước đột phá mới nhất trong ngành công nghiệp chế tạo áo giáp chống đạn. Bên cạnh sử dụng những vật liệu có độ cứng cao thì người ta còn dùng một số chất lỏng đặc biệt để tăng tính hiệu quả của chúng. Loại áo giáp này rất linh hoạt và nhẹ, người sử dụng có thể sử dụng để bảo vệ cánh tay, chân hay cổ mà không hề ảnh hưởng đến sự di chuyển của cơ thể.
Loại áo giáp lỏng này được dựa trên nền tảng của sợi Kevlar, loại sợi thường được sử dụng ở những bộ vest chống đạn. Nguyên lí hoạt động của bộ vest khá đơn giản: khi viên đạn chạm vào bề mặt bộ áo, lớp Kevlar sẽ phân tán lực tác động lên toàn bộ bề mặt và làm giảm tốc độ của viên đạn. Quá trình này cũng tương tự như túi khí ở xe hơi mở ra khi gặp chấn động vậy. Tuy nhiên, loại áo giáp này cần 20 đến 40 lớp Kevlar để có thể ngăn được một viên đạn. Chính vì thế bộ vest trở nên cứng nhắc và nặng nề ( khoảng 4,5kg), gây khó khăn cho người sử dụng. Thế nhưng với công nghệ chất lỏng mới này sẽ cho phép giảm thiểu các lớp Kevlar, khiến bộ áo giáp nhẹ hơn và linh hoạt hơn rất nhiều.
Ở đây có 2 loại chất lỏng, tương ứng với 2 loại áo chống đạn mới, đó là:
- Shear-Thickening Fluid (STF): Chất lỏng có khả năng đông cứng đột ngột khi có một lực tác động từ bên ngoài.
- Magnetorheological Fluid (MR): Chất lỏng có khả năng đông cứng đột ngột khi có tác động của từ trường.
Shear-Thickening Fluid (STF)
STF là một hỗn hợp khá đặc biệt tồn tại dưới dạng lỏng nhưng khi gặp tác động mạnh nó có thể đông cứng ngay lập tức. Thực tế, quá trình đông cứng này chỉ mất vài milli giây và khi không còn lực tác động nó sẽ trở lại trạng thái lỏng ban đầu. Nó cũng tương tự như hỗn hợp giữa bột bắp với nước. Nếu bạn khuấy hỗn hợp này từ từ, nó chả khác gì một chất lỏng thông thường. Nhưng khi bạn đập mạnh vào nó thì nó sẽ cứng như một khối bê tông.
Quá trình này được giải thích như sau: STF thực chất là một chất keo, bao gồm những hạt nhỏ lơ lửng trong nó. Những hạt này đẩy nhau liên tục, vì vậy chúng có thể nổi lên, trôi nổi trong lòng chất lỏng mà không bị chìm xuống dưới. Khi có một lực tác động vào, nó lấn át lực đẩy của các hạt này khiến chúng dính vào nhau, tạo thành một khối gọi là Hydrocluster. Khi lực bên ngoài biến mất, các hạt lại tiếp tục đẩy nhau. Khối Hydrocluster tan rã và cái chất tưởng chừng như là rắn này lại trở về trạng thái lỏng.

Khi có tác động các hạt Silica dính lấy nhau tạo thành một lớp bảo vệ vững chắc (hình dưới)
Loại chất lỏng mà các nhà nghiên cứu sử dụng trong những bộ giáp lỏng là Glyco PolyEtylen còn các hạt bên trong nó là Silica (Silic Đioxit). Silica là một thành phần của cát và thạch anh còn Glyco PolyEtylen sử dụng nhiều trong thuốc nhuận tràng hay các chất bôi trơn. Các hạt silica có đường kính chỉ khoảng một vài Nanomet, vì vậy có nhiều báo cáo mô tả chất lỏng này là một sản phẩm của công nghệ nano.
Cách tạo ra một bộ áo giáp sử dụng STF

Một chiếc áo giáp lỏng STF sau khi trúng đạn
Đầu tiên các nhà nghiên cứu pha loãng chất lỏng STF trong dung dịch ethanol. Sau đó nhúng sợi Kevlar qua hỗn hợp này rồi đặt vào lò sấy để làm bốc hơi chất ethanol. STF sẽ thấm vào các sợi Kevlar và tăng thêm độ vững chắc cho chúng. Khi có lực tác động từ bên ngoài vào lớp sợi Kevlar đã thấm STF này, chúng sẽ đông cứng lại và triệt tiêu sức mạnh của vật thể đó. Và sau khi chặn xong, lớp sợi này sẽ mềm lại như bình thường. Như vậy, không cần quá nhiều lớp Kevlar mà bộ áo giáp vẫn chắc chắn và hiệu quả. Thực tế, người ta chỉ cần 4 lớp Kevlar này thôi cũng có công dụng như 14 lớp Kevlar thông thường.
Một loại chất lỏng khác cũng dùng trong công nghệ áo giáp lỏng đó là:
Magnetorheological (MR) Fluid
Chất lỏng MR là một loại dầu và chứa các hạt sắt lơ lửng bên trong. Thông thường những hạt sắt này chiếm khoảng 20 đến 40% khối lượng chất lỏng. Các hạt này rất nhỏ, có kích thước khoảng 3 đến 10 micromet. Tuy nhỏ như vậy nhưng chúng có sức tác động mạnh mẽ lên độ cứng của chất lỏng MR. Khi tiếp xúc với từ trường, các hạt sắt sẽ dính vào nhau, thành hàng và tạo thành một lớp sắt bảo vệ vô cùng chắc chắn.

Chất lỏng MR đông cứng khi có sự tác động của từ trường
Quá trình làm đông cứng của loại chất lỏng này vào khoảng 20 phần nghìn giây. Hiệu quả đông cứng có thể khác nhau đáng kể, tất cả phụ thuộc vào thành phần chất lỏng và kích thước, hình dạng, sức mạnh của từ trường. Ví dụ các nhà nghiên cứu có thể lựa chọn những hạt sắt hình cầu, có thể trượt qua nhau dễ dàng, ngay cả khi có sự hiện diện của từ trường. Vì vậy, độ cứng của loại chất lỏng có hạt này không được đảm bảo cho lắm. Họ đang tìm ra một kết cấu hạt sắt khác để mang lại hiệu quả hơn.
Chỉ với mạt sắt và dầu là bạn tạo có thể ra một hỗn hợp có tính năng tương tự với chất lỏng MR dùng trong công nghệ áo giáp lỏng này. Khi không có từ trường, chất lỏng này di chuyển dễ dàng. Nhưng ảnh hưởng của một cục nam châm có thể biến nó trở nên dày hơn, tạo thành hình dáng nhất định như một vật thể rắn. Với một mật độ, hình dạng hạt sắt và từ trường phù hợp. chất lỏng MR có thể biến đổi thành một chất rắn vô cùng vững chắc.
Chất lỏng MR sau khi có tác động của từ trường
Cách chế tạo một bộ áo giáp từ MR cơ bản cũng tương tự như với STF, giúp tăng tính hiệu quả của bộ giáp hơn rất nhiều. Tuy nhiên một điểm yếu của bộ giáp này là phải có từ trường thì MR mới thực sự hoạt động. Ý tưởng về những cục nam châm được gắn trong bộ áo có vẻ sẽ giải quyết được vấn đề này thế nhưng nếu làm vậy, bộ giáp lúc nào cũng trong tình trạng đông cứng và nặng nề, rất khó di chuyển. Vì vậy các nhà khoa học đã gắn những mạch điện nhỏ chạy khắp bộ giáp. Nếu không có dòng điện chạy qua, bộ giáp vẫn mềm mại và linh hoạt. Nhưng khi bật công tắc, dòng điện sẽ bắt đầu di chuyển, tạo ra các từ trường kích thích các hạt sắt trong chất lỏng MR. Tắt công tắc, bộ giáp lại trở về trạng thái bình thường.
Hai loại chất lỏng này không chỉ được ứng dụng trong việc chế tạo áo giáp chống đạn mà nó còn vô vàn những ứng dụng khác. Ví dụ như chăn chống bom có thể dễ dàng gấp lại, cơ động hơn trong việc bảo vệ những người xung quanh từ sát thương của vụ nổ. Công nghệ mới này cũng có thể ứng dụng trong chế tạo giày của lính nhảy dù hay làm đồng phục cho những nhân viên bảo vệ nhà tù…
Kỹ thuật mới phát hiện dấu vân tay trên giấy ướt
Các nhà nghiên cứu ở Đại học Hebrew (HU) tại Jerusalem, Israel đã tìm ra một phương pháp mới phát hiện dấu vân tay cả trên giấy ướt, công việc mà công nghệ trước đây khó thực hiện được.
Kenguru – chiếc xe sinh ra cho người khuyết tật, chỉ có một cửa duy nhất nhưng cực tiện cho người đi xe lăn
Hãng Community Cars ở bang Texas (Mỹ) đã sáng chế ra một loại ô tô điện mang tên Kenguru, dành cho người khuyết tật phải ngồi xe lăn.
Tham vọng chế tạo Iron Man của quân đội Mỹ
Bộ Tư lệnh Lực lượng Đặc biệt của Mỹ (SOCOM) hiện đang theo đuổi một chương trình mang tính cách mạng nhằm hỗ trợ năng lực siêu nhân cho binh sĩ trong nhiệm vụ tác chiến.
Điện thoại giúp nhìn xuyên thấu mọi chất liệu
Các nhà nghiên cứu tại viện công nghệ UT Dallas mới đây đã biến những chiếc điện thoại cầm tay thành thiết bị giúp người dùng có thể nhìn xuyên thấu mọi chất liệu như tường, gỗ, nhựa, giấy…
Mỹ sắp phóng máy bay nhanh gấp 20 lần âm thanh
Trang Space.com cho hay, Cơ quan Dự án Nghiên cứu cấp cao Quốc phòng Mỹ (tức DARPA) đã lên kế hoạch phát triển và bay thử loại máy bay siêu âm có tên X-Plane tốc độ Mach 20 trong năm 2016.
Với Wysips, pin thiết bị di động không bao giờ cạn
Chúng ta đã có công nghệ cho phép định vị điện thoại khi hết pin hoặc gửi tin nhắn ngay cả khi pin cạn nguồn, nhưng bạn nghĩ sao nếu trong tương lai có thể sở hữu một chiếc điện thoại không bao giờ hết pin?


